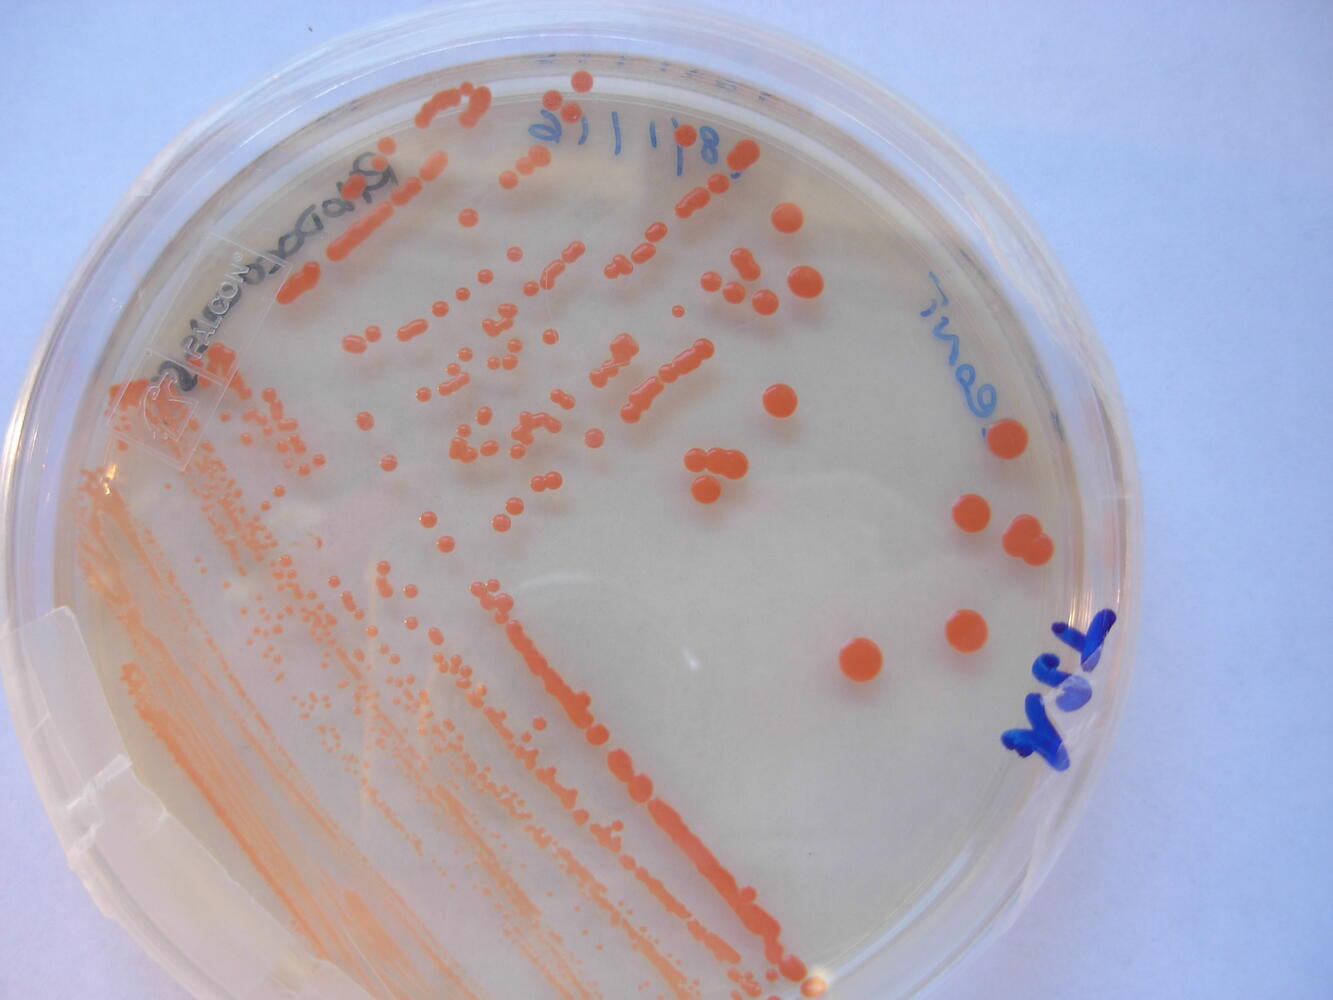

Firenze, 8 giugno 2021 - Dopo otto anni di lavoro si è conclusa la lunga campagna di restauri nella Sagrestia Nuova delle Cappelle Medicee, gioiello del gruppo Musei del Bargello.I lavori – svoltisi sotto la guida di Monica Bietti, funzionario storico dell’arte e già responsabile del Museo delle Cappelle Medicee e d’intesa con il Direttore dei Musei del Bargello, Paola D’Agostino – hanno interessato sia le tombe con le celebri statue, sia il parato della Sagrestia Nuova e sono stati condotti da un team tutto al femminile composto dalle restauratrici Daniela Manna e Marina Vincenti, con le quali hanno collaborato Donata Magrini, Barbara Salvadori e Silvia Vettori, ricercatrici dell’Istituto di Scienze del Patrimonio Culturale del Consiglio Nazionale delle Ricerche (ISPC-CNR) e Anna Rosa Sprocati e Chiara Alisi dell’ENEA (Agenzia nazionale per le nuove tecnologie, l'energia e lo sviluppo economico sostenibile).
Un lavoro che ha permesso di recuperare i valori cromatici delle pareti della Sagrestia Nuova e delle sculture e di approfondire conoscenze tecniche che ci permettono oggi di capire maggiormente le fasi costruttive e il metodo che Michelangelo applicò nella realizzazione dell’insieme. Un’impresa lunga e complessa, riuscita anche grazie ad una campagna di indagini puntuali e all’utilizzo di un’innovativa tecnica di biopulitura messa a punto dall’ENEA - utilizzata per la prima volta su dei capolavori del Buonarroti e in particolare sui sarcofagi e su parte delle sculture dei monumenti funebri di Giuliano duca di Nemours e di Lorenzo duca d’Urbino - che utilizza delle colonie di batteri per ripulire i marmi dai segni del tempo.
La Sagrestia Nuova delle Cappelle Medicee è il risultato di una straordinaria fusione fra spazio architettonico, elementi funzionali, elementi decorativi, proporzione delle forme nell’uso calibrato di pieni e di vuoti, in marmo e in pietra serena, di luce, ombre, colore e materia. Un luogo sorprendente, ultima impresa fiorentina di Michelangelo, che necessitava di un’accurata manutenzione dopo l’ultimo intervento conservativo del 1988.
Approfondimenti
Il restauro della Sagrestia ha avuto una prima breve fase di intervento sui paramenti marmorei nel 2013, ma è stato tra il 2016 e il 2020 che si sono svolti i lavori più cospicui, possibili grazie ai fondi derivati dall’autonomia dei Musei a seguito della Riforma del Ministero del 2014 che ha istituito i primi venti musei dotati di autonomia speciale, tra cui i Musei del Bargello. Inoltre, tra il 2018 e il 2019, una partnership con IGT (già Lottomatica) ha permesso sia il co-finanziamento di parte della spolveratura e restauro sia la realizzazione di una nuova illuminazione della Sagrestia Nuova.
Il lungo e complesso lavoro è stato condotto partendo dai parati marmorei e dalle paraste in pietra serena che segnano lo spazio architettonico delle pareti, per concludersi con l’intervento sulle sculture, nella seconda metà del 2020. Così come i parati marmorei anche le sculture erano coperte da depositi ed erano in più punti macchiate da residui di sostanze utilizzate in passato per proteggere le sculture durante l’esecuzione dei calchi, eseguiti dal Cinquecento a tutto l’Ottocento.
La fase di progettazione del restauro è stata preceduta e guidata dalla campagna fotografica a luce visibile di Antonio Quattrone e, tra il 2019 e il 2020, da indagini fotografiche a fluorescenza indotta da luce ultravioletta e con luci infrarosse (IR) eseguite da Andrea Rossi, operazioni che hanno accertato lo stato conservativo delle sculture e hanno permesso di selezionare le metodologie più adatte all’intervento di pulitura. In collaborazione con ISPC-CNR sono state inoltre individuate aree significative su ciascuna scultura per effettuare misurazioni colorimetriche e di riflettanza del marmo.
Nella fattispecie, il sarcofago di Lorenzo duca di Urbino era alterato da macchie di colore scuro estese lungo tutto il basamento, identificate dalle analisi eseguite dal CNR come ossalati e materiali organici e ricondotte a liquidi organici filtrati fino all'esterno del sarcofago in corrispondenza di queste macchie, da ricondursi alla sepoltura di Alessandro de’ Medici (figlio di Lorenzo duca d’Urbino), che – assassinato - fu sepolto senza essere eviscerato, come invece si usava all’epoca per la dinastia medicea.
Per l’eliminazione di queste macchie organiche e di altre di varia origine, come fosfati, gesso, tracce di silicati, tracce di ossalato di calcio, sono stati individuati alcuni ceppi batterici in grado di rimuovere selettivamente questi depositi, senza influenzare con la loro azione la materia originale, il marmo. I ceppi scelti non erano cioè in grado né di precipitare né di solubilizzare i carbonati di calcio. Dopo aver testato undici diversi ceppi batterici su piccoli tasselli di prova, sono stati scelti i tre “migliori” per procedere alla biopulitura del sarcofago.
Impacchi di cellule dei ceppi Serratia ficaria SH7, Pseudomonas stutzeri CONC11 e Rhodococcus sp Z-CONT sono stati applicati nei diversi punti del sarcofago, immobilizzati in uno speciale gel che mantiene la giusta umidità per i batteri e conferisce una giusta consistenza all’impacco, permettendo di applicarlo e di rimuoverlo facilmente, senza lasciare residui, né del supportante né delle cellule batteriche. Sono stati applicati i batteri, altamente “affamati”, per favorire il loro “appetito” verso i substrati organici da rimuovere e rendere più efficace il trattamento di biopulitura.

Paola D’Agostino, Direttore dei Musei del Bargello ha dichiarato che “Il progetto di restauro conservativo e di manutenzione che negli ultimi cinque anni e in fasi successive ha visto il coinvolgimento di diverse professionalità e di istituti di eccellenza della ricerca e innovazione scientifica italiana permette ora di ammirare i capolavori fiorentini di Michelangelo, con una nuova consapevolezza della fase delicatissima di scelta e lavorazione dei marmi. Desidero ringraziare la dottoressa Monica Bietti, le colleghe dell’Enea e del CNR, e le abili restauratrici che per mesi hanno lavorato a questo delicato restauro sperimentale.
L’autonomia dei musei, voluta dall’Onorevole Ministro Dario Franceschini, ha permesso anche di finanziare, con fondi propri, progetti di tutela, di ricerca e di alto profilo scientifico, come quello conclusosi negli ultimi mesi. Desidero inoltre esprimere la mia più sentita gratitudine all’architetto Maria Cristina Valenti, alla dottoressa Francesca De Luca e a tutto il personale che presta servizio al Museo delle Cappelle Medicee per avere seguito questo progetto e aver sempre favorito il lavoro di tutte le professioniste, anche nei durissimi mesi dell’emergenza sanitaria che ha scandito il 2020 e l’inizio del 2021”.
Come ha spiegato Monica Bietti, storica dell’arte ed ex responsabile del Museo delle Cappelle Medicee “La Sagrestia è un luogo dove all’apparenza tutto sembra perfetto: e invece le vicende di questo spazio narrano di un susseguirsi di difficoltà e abbandoni, di oblio e rinascita. Una storia vissuta come se quei marmi non fossero pietre, ma cose vive. Il restauro di uno dei luoghi simbolo dell’arte presuppone conoscenza, esperienza, metodo e scienza unite a doti di sensibilità, intelligenza e apertura al confronto.
Per questo il lavoro fin dall’inizio è stato testato e poi sottoposto a costanti verifiche ottiche, metodologiche e scientifiche. Il lavoro di restauro delle pareti ha permesso di approfondire le conoscenze tecniche sul modo di costruire o meglio sovrapporre le lastre marmoree e sulla maniera di eseguire le decorazioni figurative, vegetali e modulari, un vero e proprio esercizio che permette di distinguere le mani dei collaboratori di Michelangelo, documentati in questa impresa. Così come si comprende molto bene che dal blocco in marmo scelto da Michelangelo per ciascuna figura, egli con il metodo del “levare”, partendo da un modello in terra a grandezza naturale, trova la forma, arrivando alla finitura tramite l’uso di diversi tipi di attrezzi.
Lo stato di finitura delle sculture varia a seconda dei personaggi e anche in relazione alla loro collocazione e al rapporto con la fonte di luce. E questa è una novità e una scoperta resa possibile dal restauro”.
"A conclusione dell’intervento di restauro delle sculture e dei paramenti lapidei possiamo affermare che all’interno della Sagrestia nuova si è conservata, nei secoli, l’integrità materica di queste opere patrimonio dell’umanità – ha commentato la restauratrice Marina Vincenti -. Dopo la pulitura possiamo nuovamente godere dell’eccezionale uso della tecnica scultorea da parte di Michelangelo: espressione del suo intimo rapporto con il marmo e della sua capacità di trasformarlo in luce. Il cambio costante della tessitura dei segni lasciati dagli strumenti di lavorazione utilizzati rende vivo e palpitante il contenuto simbolico e spirituale dell’uomo chiamato a dare forma al trascorrere del tempo".
“La Sagrestia Nuova è un vero scrigno dove architettura e scultura unificano le emozioni – ha dichiarato la restauratrice Daniela Manna - I lunghi restauri, svolti nel corso di sette anni, hanno seguito una metodologia lenta, rispettosa, a volte sofferta per le condizioni ambientali del luogo, ma partendo dalle pareti hanno preparato la giusta scenografia per affrontare i restauri delle sculture del grande Michelangelo. Concreta aspirazione sarebbe quella di completare i restauri di tutti gli elementi architettonici del secondo livello per monitorare e unificare la visione d’insieme”.
Come illustrato da Silvia Vettori ricercatrice di ISPC-CNR “Il progetto diagnostico ha previsto l’impiego congiunto di metodologie non-invasive, applicate in situ, e micro-invasive, in laboratorio – ha spiegato. Le indagini hanno permesso di caratterizzare i materiali di deposito e le macchie presenti sulle superfici lapidee, come fosfati, ossalati e materiale proteico, comprendendo le problematiche legate allo stato di conservazione, e di valutare l’effetto generale delle operazioni di pulitura che si sono rivelate efficaci ma pur sempre prudenti e rispettose”.
Anna Rosa Sprocati, ricercatrice di ENEA ha inoltre aggiunto che “La selettività, la gradualità e il rispetto della materia sono qualità necessarie per una pulitura corretta. La biopulitura eseguita nel restauro delle opere di Michelangelo ha risposto a queste necessità. I batteri utilizzati sono spontanei e innocui e sono stati scelti tra un’ampia collezione di laboratorio per essere in grado di metabolizzare selettivamente i depositi coerenti identificati in precedenza dalle indagini chimiche, senza spingere oltre la loro azione. Proponiamo l’esperienza armonica condotta nella Sagrestia Nuova di Michelangelo come modello di restauro innovativo e sostenibile, che fonde storia dell’arte, restauro e scienza”.





